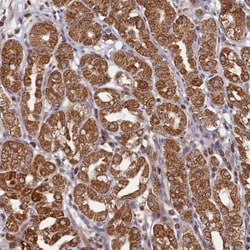
Invitrogen HAUS2 Polyclonal Antibody 100 &mu;L; Unconjugated:Antibodies,

missing translation for 'onlineSavingsMsg'
Learn More
Learn More
Invitrogen™ HAUS2 Polyclonal Antibody


Rabbit Polyclonal Antibody
Brand: Invitrogen™ PA559013
This item is not returnable.
View return policy
Description
Immunogen sequence: IPHLAANLKK MNQALAKMDI LVTETEELAE NILKWRKQQN EVSSCIPKIL AEESYLYKHD IIMPPLPFTS KVHVQTINAK Highest antigen sequence identity to the following orthologs: Mouse - 64%, Rat - 65%.
HAUS2 is 1 of 8 subunits of the 390-kD human augmin complex, or HAUS complex. The augmin complex was first identified in Drosophila, and its name comes from the Latin verb augmentare, meaning to increase. The augmin complex is a microtubule-binding complex involved in microtubule generation within the mitotic spindle and is vital to mitotic spindle assembly (Goshima et al., 2008 [PubMed 18443220]; Uehara et al., 2009 [PubMed 19369198]).
Specifications
| HAUS2 | |
| Polyclonal | |
| Unconjugated | |
| HAUS2 | |
| C15orf25; centrosomal protein 27kDa; centrosomal protein of 27 kDa; Cep27; HAUS augmin like complex subunit 2; HAUS augmin-like complex subunit 2; HAUS augmin-like complex, subunit 2; HAUS2; HsT17025 | |
| Rabbit | |
| Antigen affinity chromatography | |
| RUO | |
| 55142 | |
| Store at 4°C short term. For long term storage, store at -20°C, avoiding freeze/thaw cycles. | |
| Liquid |
| Immunohistochemistry (Paraffin), Western Blot | |
| 0.7 mg/mL | |
| PBS with 40% glycerol and 0.02% sodium azide; pH 7.2 | |
| Q9NVX0 | |
| HAUS2 | |
| Recombinant protein corresponding to Human HAUS2. Recombinant protein control fragment (Product #RP-98069). | |
| 100 μL | |
| Primary | |
| Human | |
| Antibody | |
| IgG |
Product Content Correction
Your input is important to us. Please complete this form to provide feedback related to the content on this product.
Product Title
Spot an opportunity for improvement?Share a Content Correction